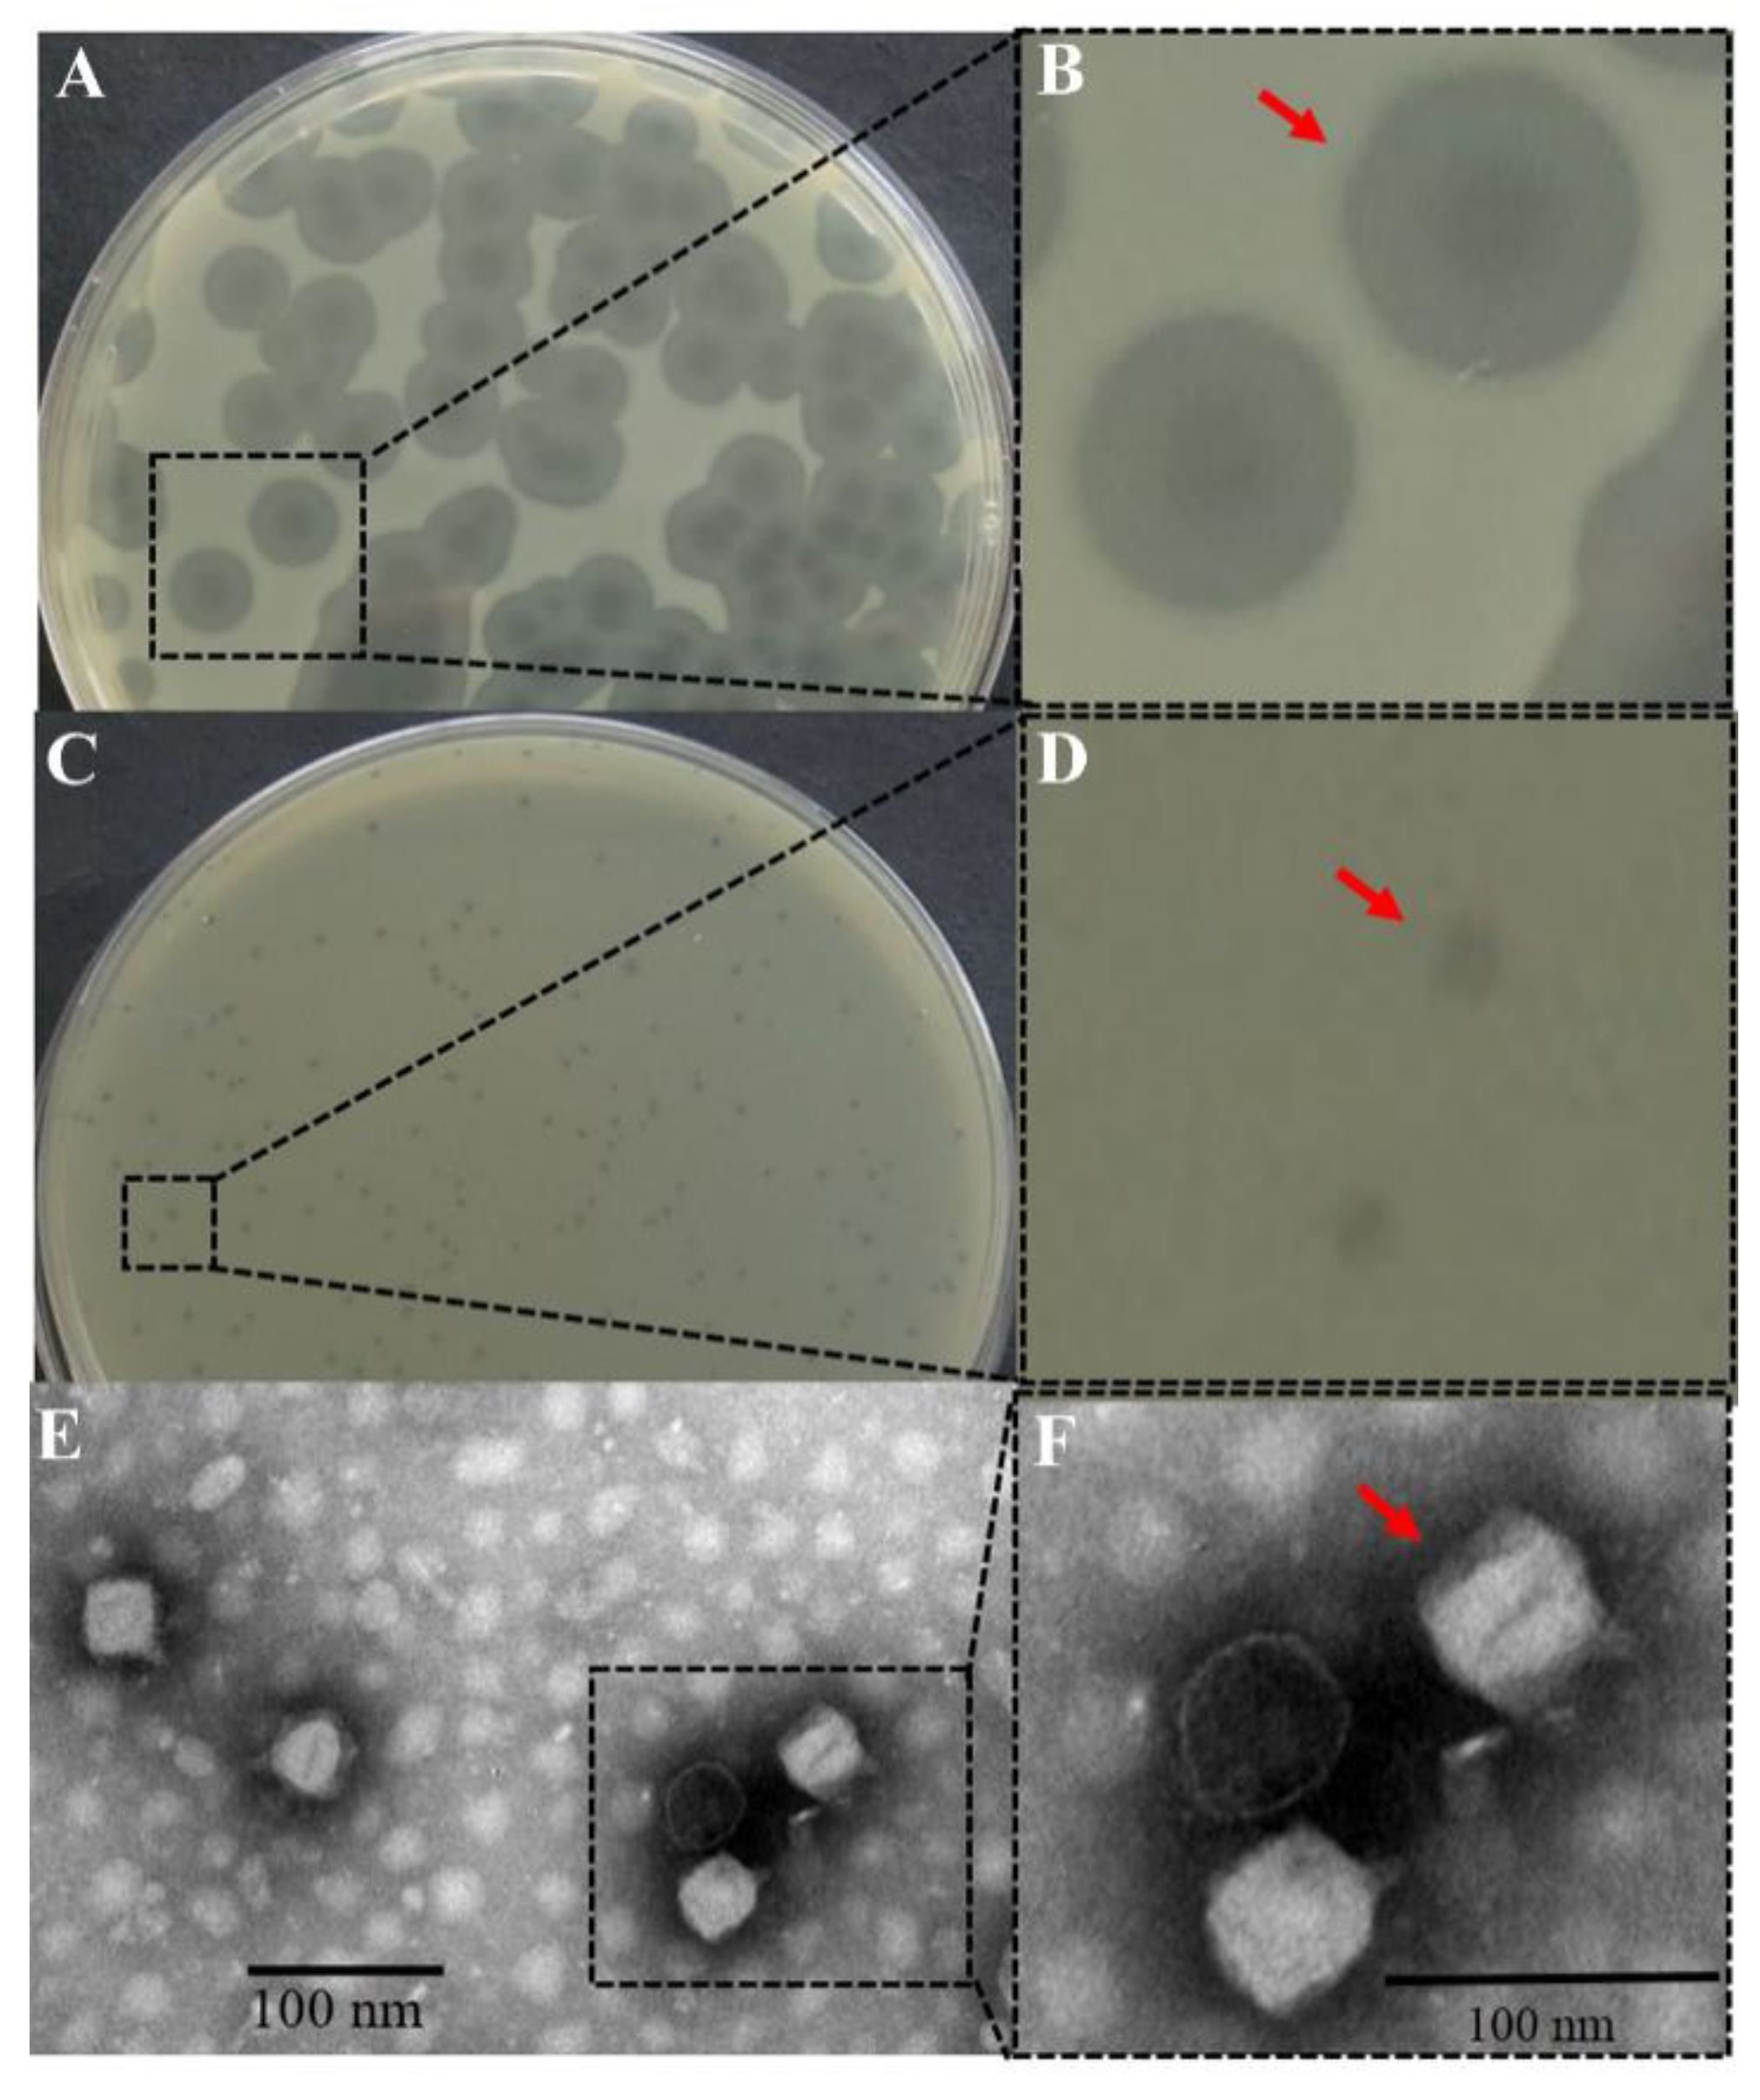
Microorganisms 08 01089 g001

Characterization of Salmonella Phage LPST153 That Effectively Targets Most Prevalent Salmonella Serovars
Abstract
1. Introduction
2. Materials and Methods
2.1. Bacterial Strains and Culture Conditions
2.2. Enrichment, Isolation, Purification, and Preparation of Phages
2.3. Morphological Observation of Phage LPST153
2.4. Spot Test
2.5. Determination of Host Range by Efficiency of Plating (EOP)
2.6. Lytic Activity
2.7. One-Step Growth Curve
2.8. pH and Thermal Tolerance of the Phage LPST153
2.9. Phage Genome Sequencing, Genome Annotation and Comparison
2.10. Biological Control of Salmonella in Foods Using Phage LPST153
2.11. Biofilm Assay in 96-Well Microplate
2.12. Statistical Analysis
3. Results
3.1. Morphology of LPST153 with Halo Zone
3.2. Host Range of LPST153
3.3. Characteristics of LPST153
3.4. Genomic Characterization of LPST153
3.5. Comparative Genome Analysis
3.6. Application of Phage LPST153 in Controlling Salmonella in Foods and Biofilms
4. Discussion
5. Conclusions
Supplementary Materials
Author Contributions
Funding
Conflicts of Interest
References
- Jajere, S.M. A review of Salmonella enterica with particular focus on the pathogenicity and virulence factors, host specificity and antimicrobial resistance including multidrug resistance. Vet. World 2019, 12, 504–521. [Google Scholar] [CrossRef] [PubMed]
- Wang, J.; Li, J.; Liu, F.; Cheng, Y.; Su, J. Characterization of Salmonella enterica isolates from diseased poultry in northern China between 2014 and 2018. Pathogens 2020, 9, 95. [Google Scholar] [CrossRef] [PubMed]
- Zhang, H.; Pan, S.; Zhang, K.; Michiels, J.; Zeng, Q.; Ding, X.; Wang, J.; Peng, H.; Bai, J.; Xuan, Y.; et al. Impact of dietary Manganese on intestinal barrier and inflammatory response in broilers challenged with Salmonella Typhimurium. Microorganisms 2020, 8, 757. [Google Scholar] [CrossRef] [PubMed]
- Mezal, E.H.; Sabol, A.; Khan, M.A.; Ali, N.; Stefanova, R.; Khan, A.A. Isolation and molecular characterization of Salmonella enterica serovar Enteritidis from poultry house and clinical samples during 2010. Food Microbiol. 2014, 38, 67–74. [Google Scholar] [CrossRef] [PubMed]
- Xiong, D.; Song, L.; Pan, Z.; Jiao, X. Identification and discrimination of Salmonella enterica Serovar Gallinarum Biovars Pullorum and Gallinarum based on a one-step multiplex PCR assay. Front. Microbiol. 2018, 9, 1718. [Google Scholar] [CrossRef] [PubMed]
- Torgerson, P.R.; Devleesschauwer, B.; Praet, N.; Speybroeck, N.; Willingham, A.L.; Kasuga, F.; Rokni, M.B.; Zhou, X.-N.; Fèvre, E.M.; Sripa, B.; et al. World Health Organization estimates of the global and regional disease burden of 11 foodborne parasitic diseases, 2010: A data synthesis. PLoS Med. 2015, 12, e1001920. [Google Scholar] [CrossRef]
- Soo Tein, N.; Cindy Shuan Ju, T.; Lay Ching, C.; Kwai Lin, T. Overview of molecular typing tools for the characterization of Salmonella enterica in Malaysia. Biomed. Environ. Sci. 2015, 28, 751–764. [Google Scholar]
- Ding, Y.; Zhang, Y.; Huang, C.; Wang, J.; Wang, X. An endolysin LysSE24 by bacteriophage LPSE1 confers specific bactericidal activity against multidrug-resistant Salmonella strains. Microorganisms 2020, 8, 737. [Google Scholar] [CrossRef]
- Felicita, M.; Gu, W.; Mahon, B.E.; Michael, J.; Jason, F.; Griffin, P.M.; Hoekstra, R.M. Estimated incidence of antimicrobial drug-resistant nontyphoidal Salmonella infections, United States, 2004–2012. Emerg. Infect. Dis. 2016, 23, 29–37. [Google Scholar]
- Hall-Stoodley, L.; Stoodley, P. Biofilm formation and dispersal and the transmission of human pathogens. Trends Microbiol. 2005, 13, 7–10. [Google Scholar] [CrossRef]
- Mizan, M.F.R.; Jahid, I.K.; Ha, S.-D. Microbial biofilms in seafood: A food-hygiene challenge. Food Microbiol. 2015, 49, 41–55. [Google Scholar] [CrossRef] [PubMed]
- Winkelströter, L.K.; Teixeira, F.B.D.R.; Silva, E.P.; Alves, V.F.; De Martinis, E.C.P. Unraveling microbial biofilms of importance for food microbiology. Microb. Ecol. 2014, 68, 35–46. [Google Scholar] [CrossRef] [PubMed]
- Han, N.; Mizan, M.F.R.; Jahid, I.K.; Ha, S.-D. Biofilm formation by Vibrio parahaemolyticus on food and food contact surfaces increases with rise in temperature. Food Control 2016, 70, 161–166. [Google Scholar] [CrossRef]
- Borie, C.; Robeson, J.; Galarce, N. Lytic bacteriophages in veterinary medicine: A therapeutic option against bacterial pathogens. Arch. Med. Vet. 2014, 46, 167–179. [Google Scholar] [CrossRef]
- García, P.; Martínez, B.; Obeso, J.M.; Rodríguez, A. Bacteriophages and their application in food safety. Lett. Appl. Microbiol. 2008, 47, 479–485. [Google Scholar]
- Summers, W.C. The strange history of phage therapy. Bacteriophage 2012, 2, 130. [Google Scholar] [CrossRef] [PubMed]
- Carlton, R.M.; Noordman, W.H.; Biswas, B.; Meester, E.D.D.; Loessner, M.J. Bacteriophage P100 for control of Listeria monocytogenes in foods: Genome sequence, bioinformatic analyses, oral toxicity study, and application. Regul. Toxicol. Pharmacol. 2005, 43, 301–312. [Google Scholar] [CrossRef]
- Greer, G.G. Bacteriophage control of foodborne bacteriat. J. Food Prot. 2005, 68, 1102. [Google Scholar] [CrossRef] [PubMed]
- O’Flynn, G.; Coffey, A.; Fitzgerald, G.F.; Ross, R.P. The newly isolated lytic bacteriophages st104a and st104b are highly virulent against Salmonella enterica. J. Appl. Microbiol. 2006, 101, 251–259. [Google Scholar] [CrossRef]
- O’Flynn, G.; Ross, R.P.; Fitzgerald, G.F.; Coffey, A. Evaluation of a cocktail of three bacteriophages for biocontrol of Escherichia coli O157:H7. Appl. Environ. Microbiol. 2004, 70, 3417–3424. [Google Scholar] [CrossRef] [PubMed]
- Abuladze, T.; Li, M.; Menetrez, M.Y.; Dean, T.; Senecal, A.; Sulakvelidze, A. Bacteriophages reduce experimental contamination of hard surfaces, tomato, spinach, broccoli, and ground beef by Escherichia coli O157:H7. Appl. Environ. Microbiol. 2008, 74, 6230–6238. [Google Scholar] [CrossRef]
- Sparvero, L.J.; Asafuadjei, D.; Rui, K.; Tang, D.; Amin, N.; Im, J.; Rutledge, R.; Lin, B.; Amoscato, A.A.; Zeh, H.J. RAGE (Receptor for Advanced Glycation Endproducts), RAGE Ligands, and their role in cancer and inflammation. J. Transl. Med. 2009, 7, 17. [Google Scholar] [CrossRef] [PubMed]
- Carter, C.D.; Parks, A.; Abuladze, T.; Li, M.; Woolston, J.; Magnone, J.; Senecal, A.; Kropinski, A.M.; Sulakvelidze, A. Bacteriophage cocktail significantly reduces Escherichia coli O157: H7 contamination of lettuce and beef, but does not protect against recontamination. Bacteriophage 2012, 2, 178. [Google Scholar] [CrossRef] [PubMed]
- Spricigo, D.A.; Bardina, C.; Cortés, P.; Llagostera, M. Use of a bacteriophage cocktail to control Salmonella in food and the food industry. Int. J. Food Microbiol. 2013, 165, 169–174. [Google Scholar] [CrossRef] [PubMed]
- Albino, L.A.; Rostagno, M.H.; Húngaro, H.M.; Mendonça, R.C. Isolation, characterization, and application of bacteriophages for Salmonella spp. biocontrol in pigs. Foodborne Pathog. Dis. 2014, 11, 602–609. [Google Scholar] [CrossRef] [PubMed]
- Bao, H.; Zhang, P.; Zhang, H.; Zhou, Y.; Zhang, L.; Wang, R. Bio-Control of Salmonella enteritidis in foods using bacteriophages. Viruses 2015, 7, 4836–4853. [Google Scholar] [CrossRef]
- Galarce, N.; Escobar, B.; Rojas, V.; Navarro, C.; Turra, G.; Robeson, J.; Borie, C. Application of a virulent bacteriophage cocktail leads to reduction of serovar Enteritidis counts in processed meat products. Biocontrol Sci. Technol. 2016, 26, 1–26. [Google Scholar] [CrossRef]
- Kim, J.H.; Kim, H.J.; Jung, S.J.; Mizan, M.F.R.; Park, S.H.; Ha, S.-D. Characterization of Salmonella spp. specific bacteriophages and their biocontrol application in chicken breast meat. J. Food Sci. 2020, 85, 526–534. [Google Scholar] [CrossRef]
- Sukumaran, A.T.; Nannapaneni, R.; Kiess, A.; Sharma, C.S. Reduction of Salmonella on chicken meat and chicken skin by combined or sequential application of lytic bacteriophage with chemical antimicrobials. Int. J. Food Microbiol. 2015, 207, 8–15. [Google Scholar] [CrossRef]
- Goodridge, L.D.; Bisha, B. Phage-Based biocontrol strategies to reduce foodborne pathogens in foods. Bacteriophage 2011, 1, 130–137. [Google Scholar] [CrossRef]
- Samson, J.E.; Magadán, A.H.; Sabri, M.; Moineau, S. Revenge of the phages: Defeating bacterial defences. Nat. Rev. Microbiol. 2013, 11, 675–687. [Google Scholar] [CrossRef]
- Doron, S.; Melamed, S.; Ofir, G.; Leavitt, A.; Lopatina, A.; Keren, M.; Amitai, G.; Sorek, R. Systematic discovery of antiphage defense systems in the microbial pangenome. Science 2018, 359, eaar4120. [Google Scholar] [CrossRef] [PubMed]
- Sillankorva, S.M. Bacteriophages and their role in food safety. Int. J. Microbiol. 2012, 1, 13. [Google Scholar] [CrossRef] [PubMed]
- Islam, M.S.; Zhou, Y.; Liang, L.; Nime, I.; Liu, K.; Yan, T.; Wang, X.; Li, J. Application of a phage cocktail for control of Salmonella in foods and reducing biofilms. Viruses 2019, 11, 841. [Google Scholar] [CrossRef]
- Islam, M.S.; Zhou, Y.; Liang, L.; Nime, I.; Yan, T.; Willias, S.P.; Mia, M.Z.; Bei, W.; Connerton, I.F.; Fischetti, V.A.; et al. Application of a broad range lytic phage LPST94 for biological control of Salmonella in foods. Microorganisms 2020, 8, 247. [Google Scholar] [CrossRef]
- Huang, C.; Virk, S.M.; Shi, J.; Zhou, Y.; Willias, S.P.; Morsy, M.K.; Abdelnabby, H.E.; Liu, J.; Wang, X.; Li, J. Isolation, characterization, and application of bacteriophage LPSE1 against Salmonella enterica in Ready to Eat (RTE) foods. Front. Microbiol. 2018, 9, 1046. [Google Scholar] [CrossRef]
- Mohammadali Khan, M.; Nilsson, A.S. Correction: Isolation of phages for phage therapy: A comparison of spot tests and efficiency of plating analyses for determination of host range and efficacy. PLoS ONE 2015, 10, e0118557. [Google Scholar]
- Wang, C.; Chen, Q.; Chong, Z.; Jie, Y.; Lu, Z.; Lu, F.; Bie, X. Characterization of a broad host-spectrum virulent Salmonella bacteriophage fmb-p1 and its application on duck meat. Virus Res. 2017, 236, 14–23. [Google Scholar] [CrossRef]
- Son, H.M.; Duc, H.M.; Masuda, Y.; Honjoh, K.I.; Miyamoto, T. Application of bacteriophage sinsimultaneously controlling Escherichia coli O157:H7 and extended-spectrum beta-lactamase producing Escherichia coli. Appl. Microbiol. Biotechnol. 2018, 102, 10259–10271. [Google Scholar] [CrossRef]
- Lópezcuevas, O.; Castrodel, C.N.; Leónfélix, J.; Gonzálezrobles, A.; Chaidez, C. Characterization of bacteriophages with a lytic effect on various Salmonella serotypes and Escherichia coli O157:H7. Can. J. Microbiol. 2011, 57, 1042. [Google Scholar] [CrossRef]
- Yan, T.; Liang, L.; Yin, P.; Zhou, Y.; Mahdy Sharoba, A.; Lu, Q.; Dong, X.; Liu, K.; Connerton, I.F.; Li, J. Application of a novel phage LPSEYT for biological control of Salmonella in foods. Microorganisms 2020, 8, 400. [Google Scholar] [CrossRef] [PubMed]
- Mount, D.W. Using the basic local alignment search tool (BLAST). CSH Protoc. 2007, 7, pdb-top17. [Google Scholar] [CrossRef]
- Jones, P.; Binns, D.; Chang, H.-Y.; Fraser, M.; Li, W.; McAnulla, C.; McWilliam, H.; Maslen, J.; Mitchell, A.; Nuka, G. InterProScan 5: Genome-Scale protein function classification. Bioinformatics 2014, 30, 1236–1240. [Google Scholar] [CrossRef] [PubMed]
- Yang, Q.; Ding, Y.; Nie, R.; Yao, L.; Wang, X.; Zhou, M.; Wang, J.; Wang, X. Characterization of a novel T7-like Salmonella Typhimurium (ATCC13311) bacteriophage LPST144 and its endolysin. LWT Food Sci. Technol. 2020, 123, 109034. [Google Scholar] [CrossRef]
- Laguerre, O.; Derens, E.; Palagos, B. Study of domestic refrigerator temperature and analysis of factors affecting temperature: A French survey. Int. J. Refrig. 2002, 25, 653–659. [Google Scholar] [CrossRef]
- Azeredo, J.; Sutherland, I. The use of phages for the removal of infectious biofilms. Curr. Pharm. Biotechnol. 2008, 9, 261–266. [Google Scholar] [CrossRef]
- Donlan, R.M. Preventing biofilms of clinically relevant organisms using bacteriophage. Trends Microbiol. 2009, 17, 66–72. [Google Scholar] [CrossRef]
- Kostaki, M.; Chorianopoulos, N.; Braxou, E.; Nychas, G.J.; Giaouris, E. Differential biofilm formation and chemical disinfection resistance of sessile cells of Listeria monocytogenes strains under monospecies and dual-species (with Salmonella enterica) conditions. Appl. Environ. Microbiol. 2012, 78, 2586–2595. [Google Scholar] [CrossRef]
- Else, T.A.; Pantle, C.R.; Amy, P.S. Boundaries for biofilm formation: Humidity and temperature. Appl. Environ. Microbiol. 2003, 69, 5006–5010. [Google Scholar] [CrossRef]
- Dakheel, K.H.; Rahim, R.A.; Neela, V.K.; Al-Obaidi, J.R.; Hun, T.G.; Isa, M.N.M.; Yusoff, K. Genomic analyses of two novel biofilm-degrading methicillin-resistant Staphylococcus aureus phages. BMC Microbiol. 2019, 19, 114. [Google Scholar] [CrossRef]
- Overbeek, R.; Olson, R.; Pusch, G.D.; Olsen, G.J.; Davis, J.J.; Disz, T.; Edwards, R.A.; Gerdes, S.; Parrello, B.; Shukla, M. The SEED and the rapid annotation of microbial genomes using Subsystems Technology (RAST). Nucleic Acids Res. 2014, 42, D206. [Google Scholar] [CrossRef] [PubMed]
- Curtin, J.J.; Donlan, R.M. Using bacteriophages to reduce formation of catheter-associated biofilms by Staphylococcus epidermidis. Antimicrob. Agents Chemother. 2006, 50, 1268–1275. [Google Scholar] [CrossRef] [PubMed]
- Islam, M.S.; Raz, A.; Liu, Y.; Elbassiony, K.R.A.; Dong, X.; Zhou, P.; Zhou, Y.; Li, J. Complete genome sequence of Aeromonas phage ZPAH7 with halo zones, isolated in China. Microbiol. Resour. Announc. 2019, 8, e01678-18. [Google Scholar] [CrossRef]
- Hughes, K.A.; Sutherland, I.W.; Clark, J.; Jones, M.V. Biofilm susceptibility to bacteriophage attack: The role of phage-borne polysaccharide depolymerase. Microbiology 1998, 144, 3039–3047. [Google Scholar] [CrossRef]
- Siringan, P.; Connerton, P.L.; Payne, R.J.H.; Connerton, I.F. Bacteriophage-Mediated dispersal of Campylobacter jejuni biofilms. Appl. Environ. Microbiol. 2011, 77, 3320–3326. [Google Scholar] [CrossRef]
- Rashid, M.H.; Revazishvili, T.; Dean, T.; Butani, A.; Verratti, K.; Bishop-Lilly, K.A.; Sozhamannan, S.; Sulakvelidze, A.; Rajanna, C. A Yersinia pestis-specific, lytic phage preparation significantly reduces viable Y. pestis on various hard surfaces experimentally contaminated with the bacterium. Bacteriophage 2012, 2, 168–177. [Google Scholar] [CrossRef]
- Careysmith, G.V.; Billington, C.; Cornelius, A.J.; Hudson, J.A.; Heinemann, J.A. Isolation and characterization of bacteriophages infecting Salmonella spp. FEMS Microbiol. Lett. 2006, 258, 182–186. [Google Scholar] [CrossRef]
- Mateus, C.; Costa, C.; Silva, Y.; Cunha, A.; Almeida, A. Efficiency of phage cocktails in the inactivation of Vibrio in aquaculture. Aquaculture 2014, 424, 167–173. [Google Scholar] [CrossRef]
- Abedon, S.T.; Herschler, T.D.; Stopar, D. Bacteriophage latent-period evolution as a response to resource availability. Appl. Environ. Microbiol. 2001, 67, 4233–4241. [Google Scholar] [CrossRef]
- Höglund, C.; Ashbolt, N.; Stenström, T.A.; Svensson, L. Viral persistence in source-separated human urine. Adv. Environ. Res. 2002, 6, 265–275. [Google Scholar] [CrossRef]
- Lingohr, E.J.; Villegas, A.; She, Y.-M.; Ceyssens, P.-J.; Kropinski, A.M. The genome and proteome of the Kluyvera bacteriophage Kvp1 another member of the T7-like Autographivirinae. Virol. J. 2008, 5, 122. [Google Scholar] [CrossRef] [PubMed]
- Chen, M.; Xu, J.; Yao, H.; Lu, C.; Zhang, W. Isolation, genome sequencing and functional analysis of two T7-like coliphages of avian pathogenic Escherichia coli. Gene 2016, 582, 47–58. [Google Scholar] [CrossRef] [PubMed]
- Steven, A.C.; Trus, B.L.; Maizel, J.V.; Unser, M.; Parry, D.A.D.; Wall, J.S.; Hainfeld, J.F.; Studier, F.W. Molecular substructure of a viral receptor-recognition protein: The gp17 tail-fiber of bacteriophage T7. J. Mol. Biol. 1988, 200, 351–365. [Google Scholar] [CrossRef]
- Hu, B.; Margolin, W.; Molineux, I.J.; Liu, J. The Bacteriophage T7 virion undergoes extensive structural remodeling during infection. Science 2013, 339, 576–579. [Google Scholar] [CrossRef]
- Molineux, I.J. No syringes please, ejection of phage T7 DNA from the virion is enzyme driven. Mol. Microbiol. 2001, 40, 1–8. [Google Scholar] [CrossRef]
- Cheng, X.; Zhang, X.; Pflugrath, J.W.; Studier, F.W. The structure of bacteriophage T7 lysozyme, a zinc amidase and an inhibitor of T7 RNA polymerase. Proc. Natl. Acad. Sci. USA 1994, 91, 4034–4038. [Google Scholar] [CrossRef]
- Jeruzalmi, D.; Steitz, T.A. Structure of T7 RNA polymerase complexed to the transcriptional inhibitor T7 lysozyme. EMBO J. 1998, 17, 4101–4113. [Google Scholar] [CrossRef]
- Krupovič, M.; Bamford, D.H. Holin of bacteriophage lambda: Structural insights into a membrane lesion. Mol. Microbiol. 2008, 69, 781–783. [Google Scholar] [CrossRef]
- Shi, Y.; Yan, Y.; Ji, W.; Du, B.; Meng, X.; Wang, H.; Sun, J. Characterization and determination of holin protein of Streptococcus suis bacteriophage SMP in heterologous host. Virol. J. 2012, 9, 70. [Google Scholar] [CrossRef]
- Rajaure, M.; Berry, J.; Kongari, R.; Cahill, J.; Young, R. Membrane fusion during phage lysis. Proc. Natl. Acad. Sci. USA 2015, 112, 5497–5502. [Google Scholar] [CrossRef]
- Berry, J.; Rajaure, M.; Pang, T.; Young, R. The spanin complex is essential for lambda lysis. J. Bacteriol. 2012, 194, 5667–5674. [Google Scholar] [CrossRef]
- Goode, D.; Allen, V.M.; Barrow, P.A. Reduction of experimental Salmonella and Campylobacter contamination of chicken skin by application of lytic bacteriophages. Appl. Environ. Microbiol. 2003, 69, 5032–5036. [Google Scholar] [CrossRef] [PubMed]
- Abedon, S.T. Ecology of anti-biofilm agents I: Antibiotics versus bacteriophages. Pharmaceuticals 2015, 8, 525–558. [Google Scholar] [CrossRef] [PubMed]
- Parasion, S.; Kwiatek, M.; Gryko, R.; Mizak, L.; Malm, A. Bacteriophages as an alternative strategy for fighting biofilm development. Pol. J. Microbiol. 2014, 63, 137–145. [Google Scholar] [CrossRef]
- Corbin, B.D.; Rjc, M.L.; Aron, G.M. Bacteriophage T4 multiplication in a glucose-limited Escherichia coli biofilm. Can. J. Microbiol. 2001, 47, 680–684. [Google Scholar] [CrossRef] [PubMed]
- Sharma, M.; Ryu, J.-H.; Beuchat, L.R. Inactivation of Escherichia coli O157:H7 in biofilm on stainless steel by treatment with an alkaline cleaner and a bacteriophage. J. Appl. Microbiol. 2010, 99, 449–459. [Google Scholar] [CrossRef] [PubMed]

| Bacteria | Source of Strains | Multidrug-Resistant | LPST153/Spot Test | LPST153/EOP |
|---|---|---|---|---|
| S. Typhimurium ATCC 14028 | ATCC | N | + | 0.18 |
| S. Typhimurium ATCC 13311 | ATCC | N | + | Host |
| S. Typhimurium LST2 (ST-8) | CI | N | + | 0.1 |
| S. Typhimurium LST4 (UK-1) | LS | N | + | 0.17 |
| S. Typhimurium LST6 (LT2) | LS | N | + | 1 |
| S. Typhimurium SGSC 4903 | SGSC | N | + | 1 |
| S. Typhimurium LST10 | LS | Y (CTT, AMP, CZO, GEN, AMK, TOB, CIP, NIT) | + | 0.004 |
| S. Typhimurium LST11 | LS | Y (CTT, AMP, CZO, GEN, AMK, TOB, CIP, SXT, NIT) | + | 0.003 |
| S. Typhimurium LST14 | LS | Y (CZO, CAZ, FEP, TOB, CRO, SXT) | + | 0.006 |
| S. Typhimurium LST17 | LS | Y (AMP, CZO, CAZ, FEP, TOB, CRO, ATM) | + | 0.005 |
| S. Typhimurium LST18 | LS | Y (CTT, AMP, CZO, GEN, AMK, TOB, CIP, SXT, NIT) | + | 0.010 |
| S. Typhimurium LST19 | LS | Y (CTT, AMP, CZO, GEN, AMK, TOB, CRO, CIP, NIT) | + | 0.016 |
| S. Enteritidis ATCC 13076 | ATCC | N | + | 0.1 |
| S. Enteritidis SJTUF 10978 | SJTU | N | + | 0.19 |
| S. Enteritidis SJTUF 10984 | SJTU | N | + | 0.17 |
| S. Enteritidis SGSC 4901 | SGSC | N | + | 0.12 |
| S. Enteritidis LSE7 | LS | Y (CTT, AMP, CZO, GEN, AMK, TOB, CIP, SXT, NIT) | + | 0.004 |
| S. Enteritidis LSE8 | LS | Y (CTT, AMP, CZO, GEN, AMK, TOB, SXT, NIT) | + | 0.1 |
| S. Enteritidis LSE10 | LS | Y (AMP, CZO, NIT) | + | 0.15 |
| S. Enteritidis LSE15 | LS | Y (AMP, CZO, GEN, AMK, TOB, NIT) | + | 0.013 |
| S. Pullorum LSP1 (CVCC 519) | LS | N | + | 0.1 |
| S. Pullorum LSP2 (CVCC 534) | LS | N | + | 0.1 |
| S. Pullorum LSP3 | LS | N | + | 0.15 |
| S. Pullorum LSP4 | LS | N | + | 0.17 |
| S. Pullorum LSP5 | LS | N | + | 0.13 |
| S. Gallinarum LSG1 | LS | N | + | 0.18 |
| S. Gallinarum LSG2 | LS | N | + | 0.1 |
| S. Gallinarum LSG3 | LS | N | + | 0.1 |
| S. Gallinarum LSG4 | LS | N | + | 0.17 |
| S. Gallinarum LSG5 | LS | N | + | 0.15 |
| S. Dublin LSD1 (3710) | LS | N | + | 0 |
| S. Dublin LSD2 (3723) | LS | N | − | 0 |
| S. Anatum ATCC 9270 | ATCC | N | − | 0 |
| S. Arizonae CDC 346-86 | CDC | N | + | 0 |
| S. Javiana LSX23 (CVM 35943) | LS | N | + | 0.03 |
| S. Kentucky LSX24 (CVM 29188) | LS | N | − | 0 |
| S. Newport E20002725 | CDC | N | − | 0 |
| S. Paratyphi B CMCC 50094 | CMCC | N | + | 0.19 |
| S. Choleraesuls ATCC 10708 | ATCC | N | + | 0 |
| S. Typhi LSX1 (CT18) | LS | N | + | 0.1 |
| S. Typhi LSX2 (Ty2) | LS | N | + | 0.1 |
| E. coli LEC1 (F18AC) | TB | N | − | 0 |
| E. coli LEC2 (C83715) | TB | N | − | 0 |
| E. coli LEC3 (T10) | TB | N | − | 0 |
| E. coli LEC4 (DH5α) | TB | N | − | 0 |
| E. coli LEC6 (BL21) | TB | N | − | 0 |
| A. hydrophila ZYAH72 | LS | N | − | 0 |
| A. hydrophila ZYAH75 | LS | N | − | 0 |
| A. hydrophila J1 | LS | N | − | 0 |
| A. hydrophila ZYAH91 (D4) | LS | N | − | 0 |
| C. sakazakii ATCC 12868 | ATCC | N | − | 0 |
| C. sakazakii ATCC 29004 | ATCC | N | − | 0 |
| C. sakazakii ATCC 29544 | ATCC | N | − | 0 |
| S. flexneri CMCC 51572 | CMCC | N | − | 0 |
| V. parahaemolyticus ATCC 17802 | ATCC | N | − | 0 |
| V. parahaemolyticus ATCC 33846 | ATCC | N | − | 0 |
| P. aeruginosa ATCC 7853 | ATCC | N | − | 0 |
| S. aureus ATCC 6538 | ATCC | N | − | 0 |
| S. aureus ATCC 8095 | ATCC | N | − | 0 |
| S. aureus ATCC 29213 | ATCC | N | − | 0 |
| Listeria ATCC 19114 | ATCC | N | − | 0 |
| Listeria ATCC 19115 | ATCC | N | − | 0 |
| Streptococcus suis LSM122 (P1/7) | LS | N | − | 0 |
| Streptococcus suis LSM123 (SC19) | LS | N | − | 0 |
| L. acidophilus ATCC SD5221 | ATCC | N | − | 0 |
© 2020 by the authors. Licensee MDPI, Basel, Switzerland. This article is an open access article distributed under the terms and conditions of the Creative Commons Attribution (CC BY) license (http://creativecommons.org/licenses/by/4.0/).
Share and Cite
Islam, M.S.; Hu, Y.; Mizan, M.F.R.; Yan, T.; Nime, I.; Zhou, Y.; Li, J. Characterization of Salmonella Phage LPST153 That Effectively Targets Most Prevalent Salmonella Serovars. Microorganisms 2020, 8, 1089. https://doi.org/10.3390/microorganisms8071089
Islam MS, Hu Y, Mizan MFR, Yan T, Nime I, Zhou Y, Li J. Characterization of Salmonella Phage LPST153 That Effectively Targets Most Prevalent Salmonella Serovars. Microorganisms. 2020; 8(7):1089. https://doi.org/10.3390/microorganisms8071089
Chicago/Turabian StyleIslam, Md. Sharifull, Yang Hu, Md. Furkanur Rahaman Mizan, Ting Yan, Ishatur Nime, Yang Zhou, and Jinquan Li. 2020. "Characterization of Salmonella Phage LPST153 That Effectively Targets Most Prevalent Salmonella Serovars" Microorganisms 8, no. 7: 1089. https://doi.org/10.3390/microorganisms8071089
APA StyleIslam, M. S., Hu, Y., Mizan, M. F. R., Yan, T., Nime, I., Zhou, Y., & Li, J. (2020). Characterization of Salmonella Phage LPST153 That Effectively Targets Most Prevalent Salmonella Serovars. Microorganisms, 8(7), 1089. https://doi.org/10.3390/microorganisms8071089

